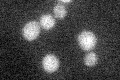
YKR080W
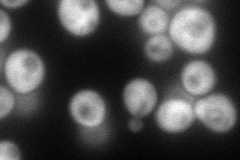
YKR080W
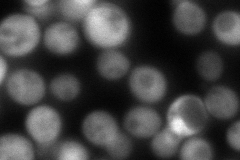
YKR080W

View description
NAD-dependent 5,10-methylenetetrahydrafolate dehydrogenase, plays a catalytic role in oxidation of cytoplasmic one-carbon units; expression is regulated by Bas1p and Bas2p, repressed by adenine, and may be induced by inositol and choline
Localization:
Intensity:
Fold change:
Significance:
-
C’ GFP library in SD
below threshold16.58 -
N' NOP1pr-GFP in SD
cytosol118.937 -
N' TEF2pr-mCherry in SD

cytosol177.115 -
N' NATIVEpr-GFP in SD
cytosol187.29 -
N' TEF2pr-VC and Cyto-VN in SD

#N/A0 -
C’ GFP library in SD+DTT

cytosol17.791.07No -
C’ GFP library in SD+H2O2

cytosol17.031.02No -
C’ GFP library in Starvation Media

cytosol16.270.98No -
C’ GFP library on the background of Pup2-DaMP

below threshold -
C’ GFP library on the background of CCT mutant

below threshold17.36081.04632No
